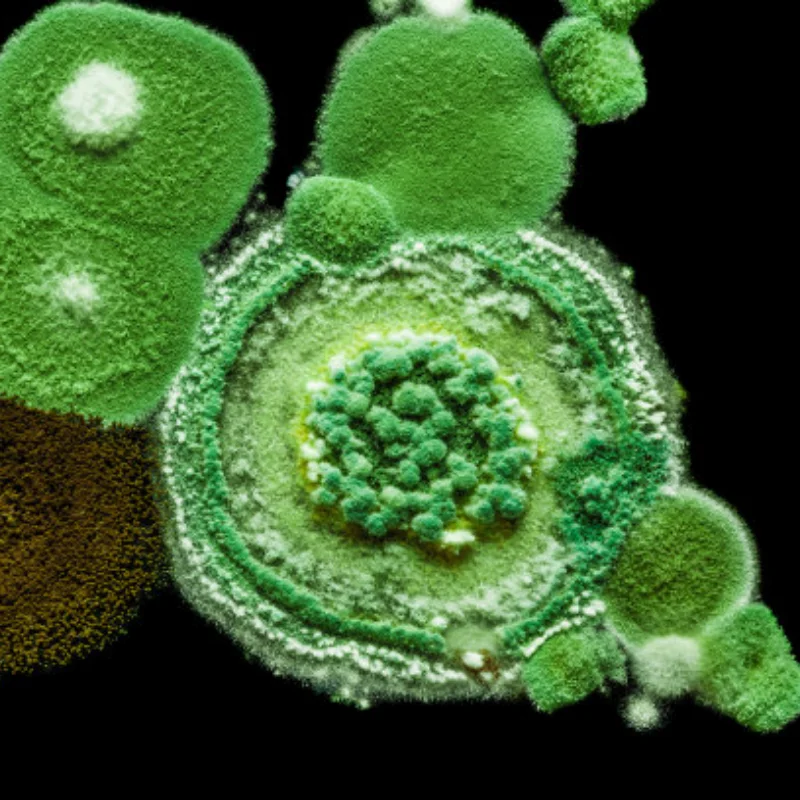
VX 18CXP Vertex 18 Engine Nitro Power 2.74cc With Pull Starter Spark-plug 02060 for 1/10 1/8 RC Model Car Buggy HSP Himoto

Ремень зубчатый ГРМ (производство ContiTech) ФОРД ЮСA,МАЗДА,323 5,626 4,КСЕДОС 6,КСЕДОС 9,МX-3,МX-6,ПРОБ

артикул: 1427194450
СОГЛАСНО НАШИМ ДАННЫМ, ЭТОТ ПРОДУКТ СЕЙЧАС НЕ ДОСТУПЕН
672.76 грн.
Доставка из: Украина
Описание
Описание загружается
График изменения цены & курс обмена валют
Пользователи также просматривали

1,880.90 грн.
18650Battery 36V 30Ah Scooter Battery Pack for M365 36V 30000mAh 18650Battery Pack Scooter bicycle BMS Board For+Free Shipping
aliexpress.com
3,591.07 грн.
Искусство для гостиной стена тутового дерева картины Винсента Ван Гога высокое качество ручная роспись
aliexpress.ru
1,017.61 грн.
mens designer fashion hat womens baseball cap fitted hats letter summer snapback sunshade sport embroidery casquette beach luxury hats adjus, Blue;gray
dhgate.com
3,481.74 грн.
New Motorcycle Air Damper Small Side Panel Carbon Fiber Twill Weave Gloss For S1000RR S 1000 RR S 1000RR 2019 2020+
aliexpress.com
235.90 грн.
925 Sterling Silver Charm For Bracelet Necklace Dangle Charms Cat Holding Moon Pendant Beads Pendants Diy Jewelry Gift For Women Girls
temu.com
80.74 грн.
50pcs Transparent Graffiti Decoration Stickers For Laptop Water Bottle Luggage Helmet Skateboard Stationery Motorcycle Guitar, Christmas Gift, Reward Gift
temu.com
686.33 грн.
1pc Fil de Dentelle Mélangé, Fil de Gâteau à , Teinture Dégradée, Fil pour Châle Écharpe Pull Printemps Été, Fournitures de Couture Artisanale, Fournitures de Crochet 300g
temu.com
1,219.87 грн.
Dark Plstar 3D Printed Hockey Custom Name Satan Gift Harajuku Streetwear Pullover Casual Unisex Hoodies Sweatshirt Zip Style 1 220704
dhgate.com
502.50 грн.
2Pack Kinesiology Tapes Elastic Athletics Sport Tape Athletic Strapping Knee Brace Support Gym Tennis Fitness Muscle Pain Care, Red
dhgate.com
264.92 грн.
For Samsung Galaxy Tab S8 Wi-Fi SM-X700 Outer Card Slot Design Anti-fall PU Leather Wallet Stand Tablet Case Cover with Pen Slot - Wine Red
tvc-mall.com
63.92 грн.
My Hero Academia Battle Action Case For Apple iPhone 14 13 12 11 Pro Max 13 12 Mini XS Max XR X 7 8 6 6S Plus Cover Shell
aliexpress.ru
1,807.73 грн.
2 шт. автомобильный Стайлинг H4 H7 9005 светодиодные фары 6000 К 80 Вт 8000LM COB светодиодные фары головного света, противотуманные фары, бордовый Conversion...
aliexpress.ru
1,162.68 грн.
Heavy Duty Universal Slide Front & Rear Sight Pusher for SIG Aluminum Alloy
aliexpress.com
150.96 грн.
For iPhone 14 12 11 Pro Max 14 Plus 12 Mini Case Green Pleated Oil Painting Phone Case Soft Silcone Shockproof Cover
aliexpress.ru
78.21 грн.
Nail sticker accessories 3d gilding nail sticker cute flame small decal DIY nail sticker water decal nail art decoracion de uñas
aliexpress.ru
150.12 грн.
8 Pcs Bottle Drip Rings Stainless Steel Collar Collar Stainless Steel Bottle Collar
aliexpress.ru
845.63 грн.
1 шт. ИК 3025 первичный заряжающий ролик PCR для Canon IR3025 IR3030 IR3035 IR3045 IR3225 IR3230 IR3235 IR3245 совместимый высокое качество
aliexpress.ru
374.24 грн.
Умная розетка Zigbee с таймером и голосовым управлением, умная розетка с дистанционным управлением, работает с Alexa Google Home
aliexpress.ru
217.40 грн.
Вращающаяся на 360 градусов Нескользящая полка для специй, кухонный шкаф с поворотным механизмом, органайзер для хранения, лоток, кухонные ак...
aliexpress.ru
66.44 грн.
Гибкая светодиодная ленсветильник, 1 шт, 12 В постоянного тока, 60 лм, 30 см, 15SMD, автомобильная Водонепроницаемая светодиодная лента для окружаю...
aliexpress.ru
819.13 грн.
9 juju smith-schuster kansas''city''chiefs''men women youth 15 patrick mahomes 10 tyreek hill 32 tyrann mathie, Black;red
dhgate.com
653.88 грн.
СВЕТОДИОДНАЯ Гирлянда в виде снеговика на рождественскую елку, 2 м, 20 светодиодов, Рождественское украшение для дома, 2021, рождественские укр...
aliexpress.ru
538.24 грн.
Кварцевые часы с ракушками, бесшумные наручные часы для рыбалки, стальной дизайн, новые женские наручные часы
aliexpress.com
489.88 грн.
Замок для детской безопасности, многофункциональные замки на дверцы шкафов, ящиков, холодильников, шкафов, унитазов, для ухода за детьми, за...
aliexpress.ru
735.03 грн.
Jubba Thobe Islamic Clothing Muslim Qamis Men Robe Ramadan Costumes Arabic Pakistan Saudi Arabia Dubai Abaya Full Sleeve Kaftan
aliexpress.com
310.75 грн.
5Pcs Full Cover Tempered Glass For 11 Pro Max Explosion-Proof Screen Protector Film For iPhone XR XS 12 Pro Max x 7 8Plus 12mini
aliexpress.com
608.88 грн.
Sexy Dress Women Deep V-neck Long Sleeve Slim Dresses Female Solid Loose Summer Split Fork Maxi Casual Dress Lugentolo
aliexpress.com
263.65 грн.
Camiseta personalizada de manga corta con cuello redondo para hombre, camiseta de hip hop de tendencia de primavera
aliexpress.ru
2,000.74 грн.
D-shaped Non-Electric Smart Toilet Seat, Non-Electric Cleaning Eco Seat Comfortable Elongated Toilet Seat Bidet Attachment,White
aliexpress.com
9,534.00 грн.
200-0430-141 NOZZLE ASSEMBLY 60u used for Willett 430 405 407 Videojet 43s inkjet coding printer
aliexpress.com
2,819.03 грн.
KLoRe X N69HD 20th Anniversary Bla Silk Tang Suit Jaet Dragon Print Loose Fit Long Sve Youthful ular Outerwear
aliexpress.com